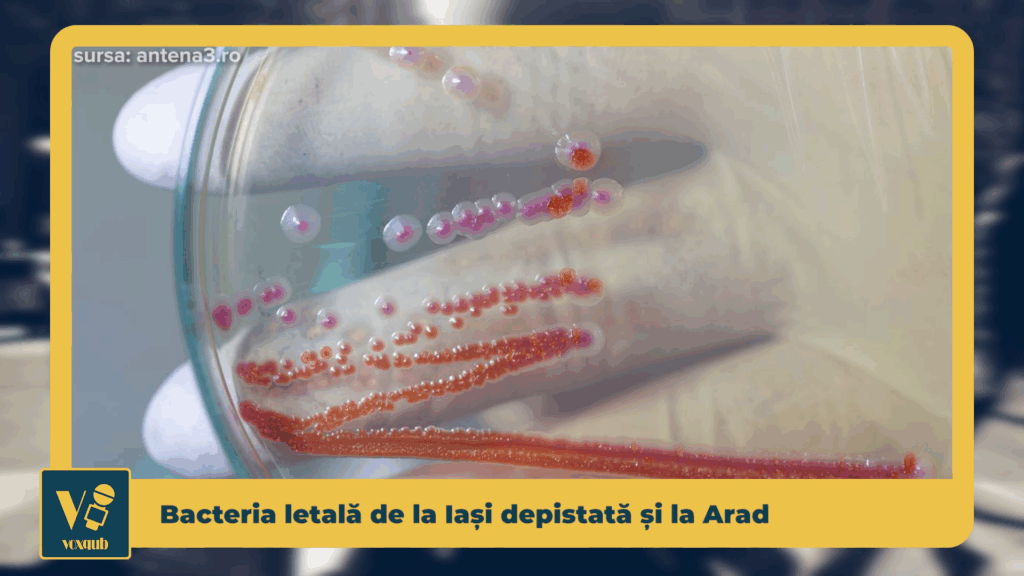

Bacteria Serratia marcescens, care a provocat decesul mai multor copii la Iași, a fost identificată și la Spitalul Județean din Arad. Autoritățile confirmă existența a doi pacienți infectați, aflați pe secții diferite, sub tratament medical. Direcția de Sănătate Publică monitorizează atent situația, iar prefectura a dispus controale în toate spitalele din județ, pentru verificarea respectării protocoalelor de igienă și a măsurilor de prevenire a infecțiilor nosocomiale.
Bacteria letală de la Iași depistată și la Arad – VoxQub
Dată
DISTRIBUIE
„România și interesul național : un proiect geopolitic pentru prezent și viitor” – MozaiQub
aprilie 1, 2026
Lansarea volumului „România și interesul național românesc în contextul dezordinii mondiale actuale – proiect geopolitic”, semnat de prof. univ. dr. Adrian Severin, eveniment găzduit la ...
Investiția în tineret, cheia performanței pe termen lung – VoxQub
aprilie 1, 2026
Timișoara devine, începând de miercuri, gazda turneului semifinal destinat juniorilor I, o competiție care aduce față în față unele dintre cele mai promițătoare echipe de ...
Știri pe scurt – Miercuri, 01 aprilie, ora 17:00
aprilie 1, 2026
Știri pe scurt - Miercuri, 01 aprilie, ora 17:00
Între familie și tratament: povestea îngrijirii la domiciliu – Rețeta Compensată
aprilie 1, 2026
Între familie și tratament: povestea îngrijirii la domiciliu - Rețeta Compensată





